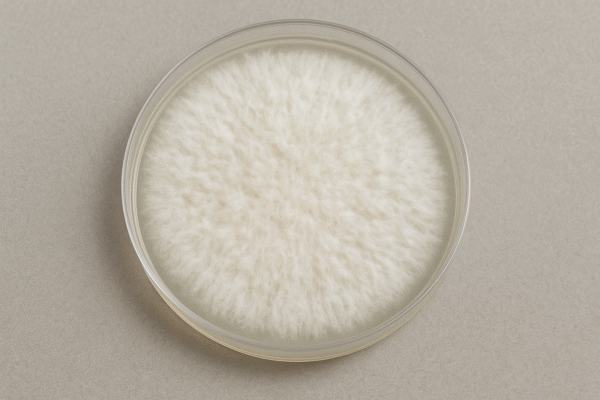
Tablas Petri

Tablas Petri
₡26,000.00
Las placas Petri con micelio son una herramienta esencial en el cultivo de hongos, especialmente para quienes buscan trabajar con cultivos puros y de alta calidad. Cada placa contiene micelio vivo y activo, desarrollado sobre agar nutritivo estéril, listo para ser transferido a nuevos medios o sustratos.
Este formato permite preservar genéticas específicas, seleccionar micelios vigorosos y realizar expansiones limpias para preparar cultivos líquidos, jeringas o granos colonizados. Todas las placas son preparadas bajo flujo laminar, garantizando un ambiente 100% estéril y libre de contaminantes.
Características del Producto:
-
Micelio vivo, saludable y listo para propagar.
-
Cultivo puro y libre de contaminantes.
-
Ideal para transferencias a agar, granos o líquidos.
-
Permite conservar y replicar genéticas seleccionadas.
-
Perfecta para micólogos principiantes y avanzados.




